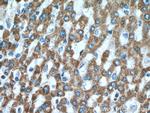
MUT Antibody in Immunohistochemistry (Paraffin) (IHC (P))

Search
Proteintech
MUT Polyclonal Antibody
{{$productOrderCtrl.translations['antibody.pdp.commerceCard.promotion.promotions']}}
{{$productOrderCtrl.translations['antibody.pdp.commerceCard.promotion.viewpromo']}}
{{$productOrderCtrl.translations['antibody.pdp.commerceCard.promotion.promocode']}}: {{promo.promoCode}} {{promo.promoTitle}} {{promo.promoDescription}}. {{$productOrderCtrl.translations['antibody.pdp.commerceCard.promotion.learnmore']}}
产品信息
17034-1-AP
种属反应
宿主/亚型
分类
类型
抗原
偶联物
形式
浓度
规格
纯化类型
保存液
内含物
保存条件
运输条件
产品详细信息
Immunogen sequence: SARIARNTQ IIIQEESGIP KVADPWGGSY MMECLTNDVY DAALKLINEI EEMGGMAKAV AEGIPKLRIE ECAARRQARI DSGSEVIVGV NKYQLEKEDT VEVLAIDNTS VRNRQIEKLK KIKSSRDQAL AERCLAALTE CAASGDGNIL ALAVDASRAR CTVGEITDAL KKVFGEHKAN DRMVSGAYRQ EFGESKEITS AIKRVHKFME REGRRPRLLV AKMGQDGHDR GAKVIATGFA DLGFDVDIGP LFQTPREVAQ QAVDADVHAV GVSTLAAGHK TLVPELIKEL NSLGRPDILV MCGGVIPPQD YEFLFEVGVS NVFGPGTRIP KAAVQVLDDI EKCLEKKQQS V (401-750 aa encoded by BC016282)
靶标信息
The product of this gene is a Golgi enzyme catalyzing an essential step in the conversion of oligomannose to complex N-glycans. The enzyme has the typical glycosyltransferase domains: a short N-terminal cytoplasmic domain, a hydrophobic non-cleavable signal-anchor domain, and a C-terminal catalytic domain. Mutations in this gene may lead to carbohydrate-deficient glycoprotein syndrome, type II. The coding region of this gene is intronless. Transcript variants with a spliced 5' UTR may exist, but their biological validity has not been determined.
仅用于科研。不用于诊断过程。未经明确授权不得转售。
生物信息学
蛋白别名: MCM; methylmalonyl CoA mutase; methylmalonyl Coenzyme A mutase; Methylmalonyl-CoA isomerase; methylmalonyl-CoA mutase c.*192delA; methylmalonyl-CoA mutase c.*51C>G; methylmalonyl-CoA mutase variant c.1495G>A; methylmalonyl-CoA mutase variant c.2011A>G; methylmalonyl-CoA mutase variant c.2150G>T; methylmalonyl-CoA mutase variant c.322C>T; methylmalonyl-CoA mutase variant c.613_615delGAA; methylmalonyl-CoA mutase variant c.636G>A; methylmalonyl-CoA mutase variant c.643G>A; Methylmalonyl-CoA mutase, mitochondrial; methylmalonyl-Coenzyme A mutase; mutant methylmalonyl CoA mutase; unnamed protein product
基因别名: D230010K02Rik; MCM; MMUT; MUT
UniProt ID: (Human) P22033, (Mouse) P16332
Entrez Gene ID: (Human) 4594, (Mouse) 17850, (Rat) 688517